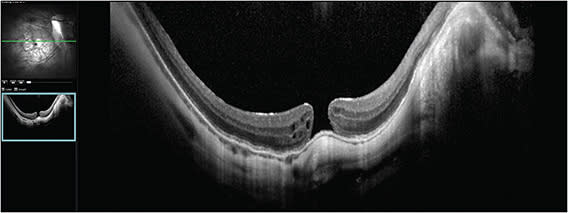
Figure 1. Optical coherence tomography image of a recurrent myopic macular hole of approximately 200 µm in the right eye of a 48-year-old male patient. Visual acuity was 20/64, the patient was pseudophakic, and the axial length was 34 mm.

Retina specialists are increasingly seeing patients in the operating room who require complex procedures. Retinal Physician convened a roundtable of surgeons experienced in complex surgical cases to present and discuss approaches to a series of difficult cases.
Dr. Vajzovic: This is a case of recurrent myopic macular hole in a 48-year-old male patient who had a long-standing history of degenerative myopia. His axial length is 34 mm. Interestingly, he had prophylactic macular buckle surgery performed in both eyes in 2012. Before seeing this patient, I didn’t know macular buckles were performed prophylactically in the United States. He had cataract extraction done, and unfortunately he developed myopic macular hole in the right eye. He underwent primary vitrectomy and membrane peeling with shorter-acting gas in 2016. At that time, the hole closed and his vision was back to 20/20. Then the hole reopened a few months later and he underwent secondary vitrectomy and membrane peel. The hole closed again, then 3 years later it reopened and he underwent surgery again with longer-acting gas. Each time a membrane peeling was performed. This time, the hole did not close. On the optical coherence tomography (OCT) taken at presentation, the macular hole size was 200 µm, which is not huge, and edges were everted with cystic changes, which is a good prognostic sign (Figure 1). At this point, he was already on drops and he was tried on topical therapy after the last procedure. However, looking at this, topical therapy alone likely will not be the fix. His visual acuity is 20/64, which is remarkably good after all the prior macular hole surgeries. I was really intrigued by that. I questioned whether that macular buckle was actually well positioned and doing him any good or if it had something to do with the hole reopening. The OCT did not show thick epiretinal membranes or anything more concerning than that. There is quite a myopic fundus with peripapillary atrophy and staphyloma as well.
To approach this case, we need to decide on instrumentation. The axial length of 34 mm is longer than our standard forceps, which are usually about 32 mm. Finesse Flex Loop (Alcon) comes in handy in these cases, because we can extend it a little further, but in general visibility in these cases is challenging. It’s also difficult to visualize the internal limiting membrane (ILM) or epiretinal membrane as you reflect your light off of the very whiteish macular staphyloma. Would you do anything with the macular buckle? Would you opt for a 25-gauge or 23-gauge vitrectomy? What type of technique, gas, visualization, and lighting would you use?
Dr. Kaiser: First, I consider that this is a fifth surgery. I like that the patient has a macular buckle. For difficult myopic cases, especially when the hole has reopened, I inject sub-Tenon, basically subfoveal Healon (Johnson & Johnson) to produce an effect at least temporarily. It can last 2 to 3 days, which is good enough to help close the hole. That macular buckle in this case is a little bit off, but I would definitely not remove it. I like to use ILM for these types of cases, and if you’ve had 4 peels that means you’re going to do some sort of free flap. You might pull it over or do a flap transplantation by bringing it from somewhere. This can be difficult, but as you said, by looking at the OCT it doesn’t look like there’s any kind of traction yet. Another consideration is gently redetaching the retina, gently irrigating underneath, and causing the hole to elevate to allow it to close a little bit better.
Dr. Weng: This is a really challenging case and you could go about it a number of different ways. I do not have much experience with macular buckles because they are not commonplace here in the United States, but based on images I have seen, the imbrication isn’t usually so focal. I agree with Dr. Kaiser that it looks a little bit odd here, but I’d probably elect to leave the buckle in place. After 4 prior surgeries, I am not sure there would be sufficient remaining ILM for an ILM flap technique, but I think that performing an autologous retinal transplant is a good option here. I would create a subretinal bleb near the nerve, maybe in the nasal or inferonasal posterior pole, and then cut out a graft. This myopic macular hole appears pretty small, so you’d only need a 300-µm to 400-µm diameter piece of autologous retina. I prefer to inject perfluoro-n-octane so that I can mobilize the graft to the macular hole site in a controlled and stable manner. No need to force it in; simply lay the graft over the hole surface. Recently, some larger series have demonstrated success in this specific situation with recurrent refractory myopic macular hole.1
One pearl for the reader is that in these eyes with long axial lengths, you can remove the vitrectomy port and insert your instruments directly through the sclerotomy. That might give you the extra couple of millimeters that you need to more comfortably and safely reach your target.
Dr. Murray: I think both the Flex Loop and graft suggestions are excellent. I think the macular buckle is unusual, but I would not touch it and I think it’s giving you a relatively positive effect. I do see membrane on your OCT so I don’t know if that’s residual ILM or it’s recurrent membrane. In these eyes for me, I’m surprised that the vision is this good: 20/64 after 4 operations, not counting the cataract and macular buckle, this eye has had 6 surgical procedures. If the vision was worse, I would be a little more comfortable using a translocation technique. I think what I would do instead is to go back to some of the things we’ve done previously and have been recently re-reported. I would stain, using any stain, but I use ICG, and I would leave it on for longer than I normally do, and I would make sure that I achieve staining somewhere out in the periphery. Then I would use a membrane peeling technique and to get back there I would start with the Flex Loop. I like the idea of taking out the trocar, but the other technique that I like is to decrease the intraocular pressure. These eyes usually have no significant scleral rigidity. You can collapse the eye inward without compromising your view. If I was able to, I’d use a macular contact lens for the membrane peeling component of this. If not, I think you can get excellent viewing widefield without using a macular contact lens. Another technique that has resurged is to use viscodissection of the hole where you put a viscoelastic under the edge to redetach the retina, as Dr. Kaiser suggested. I would do that after I had peeled the ILM. Then, you can take peripheral ILM if there’s no macular ILM available, and bring that over, perform air–fluid exchange, and put this eye under gas.
If you watch these patients serially and you inject the eye before the hole coalesces when there’s intraretinal edema, you can manipulate the hole progression to prevent the hole formation. Dr. Vajzovic, you said this patient was on topical drops. I’m assuming that’s dorzolamide or a dorzolamide derivative; I like that a lot. For my patients who have leakage on dorzolamide, I inject them in the hopes of never letting them get to this stage.
Dr. Khanani: I always restain also, even though patients like this have had so many surgeries. I have used BBG for 10 years. I think the hole is small enough that autologous transplantation would work, but I’ve not done it. I think lifting and opening the hole as suggested with Healon, getting a peripheral ILM piece to insert, and using C3F8 with face-down positioning should close the hole. Sometimes it’s very difficult to peel the ILM because the retina is so thin and you can get iatrogenic break. So that’s why you need very good staining and to be patient. However, because of the size of this hole, I would close with the ILM flap.
Dr. Vajzovic: I did not touch the buckle. I agree that on OCT it looked questionable as to whether it was contributing to the reopening of the macular hole, but I have seen macular buckle work well for patients, so I opted to leave it. I ended up doing a combination of 25-gauge and 23-gauge surgery, primarily because I chose to use a myopic fine-tip Eckhardt forceps by Bausch + Lomb that has a 37-mm length shaft, and I find that very helpful in these very myopic eyes. It gives that extra few millimeters to reach the posterior pole. And echoing Dr. Weng’s and Dr. Murray’s comments, in terms of lowering pressure, taking out the trocars is beneficial to reach the back in these myopic eyes. I find it challenging at times to visualize with widefield or contact lens because, as you’re pressing on the sclerotomy, you actually dislodge the lens to the side. So, I wish there were a more narrow lens for these type of cases. Oculus surgical is coming out with a myopic/pediatric disposable lens, which will be helpful for these kinds of cases.
In terms of staining, I’ve also recently switched to BBG for most of my cases. However, in these myopic eyes, I find it challenging to see blue on this very pale fundus, so I find ICG stains the ILM well. Also, lowering the light settings helps to visualize the posterior pole better. In general, I would say the case went really well. I found it helpful to stain with ICG in this case, and there was actually residual ILM as well as epiretinal membrane on OCT.
I was able to reach the macula with combination of Flex Loop and myopic forceps. I didn’t think it was helpful to use ILM as a flap because it was not quite continuous. I extended the peel even more broadly to the arcades and little past those. I did a fluid–air exchange and filled the eye with gas. I choose gas for these cases over silicone oil because I have had patients who are very myopic and silicone oil does not quite tamponade, and with the staphyloma, there might be a pocket of fluid in between that silicone oil and the retina. I’ve also found that longer-acting gas and 1 week of positioning has helped closure of myopic holes. For this patient, the OCT image taken 1 week after surgery through a gas-filled eye showed that the hole had closed (Figure 2).

Dr. Murray: That’s a beautiful picture. None of us suture anymore, but this is a case where you really need to think about suturing the myopic sites, or you can have lots of gas with underfill. At 1 week for me with that eye, I would not make my patient continue face down any longer with documentation of hole closure. Many of us aren’t keeping our patients face down even for a week, but in a complex eye like this, I would have told the patient to be face down religiously for a week and that would have been the best news I would share with the patient when I was able to see that OCT image.
Dr. Vajzovic: Yes, I had the patient do exactly 1 week of face-down positioning, primarily because this is the fifth surgery, with long-acting gas, and I wanted to make sure that we did everything possible. And at 1 week imaging I was able to share with the patient the excitement that we’re seeing it close, hopefully. We will have to see what happens when the gas is gone, but there is still pretty good fill in the eye, also.
Dr. Kaiser: Great result. Thank you to the panel for this excellent discussion. RP
REFERENCES
- Moysidis SN, Koulisis N, Adrean SD, et al. Autologous retinal transplantation for primary and refractory macular holes and macular hole retinal detachments: the global consortium. Ophthalmology. 2021;128(5):672-685. doi:10.1016/j.ophtha.2020.10.007








